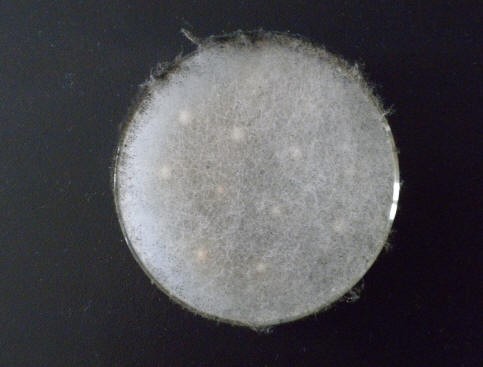

诱导产孢专用紫外光源
我公司提供诱导产孢专用紫外光源
美国路阳是专业生产紫外线光源的厂家,产品被广泛应用到高校、研究所、企业技术开发中心等行业。特别是在高校以及研究所做诱导产孢以及光催化反应用,美国路阳在这个行业拥有60%的市场份额。
美国路阳生产有254nm,302nm、365nm等多种光源,有专门为诱导产孢用的紫外线光源,照射面积、波长以及强度特别适合诱导产孢用。在选用诱导产孢紫外线光源时,如果波长选择错误,会造成培养的菌种大面积坏死,给实验造成严重的后果,如果选择的紫外线强度过高,同样会造成菌种坏死,如果选择紫外线强度过低,那么菌种产孢的时间会大大加长,有的甚至没有效果。美国路阳生产的诱导产孢紫外光源,配有专用支架,特别适合照射在培养皿里面培养的菌种。
备注:培养皿一定要用专用的培养皿,否则,很多培养皿会隔离掉紫外线。
目前,已经在诱导产孢专用紫外光源上海交大、北京理工大学、山东大学、南京农大等高校得到了成功应用,如对诱导产孢专用紫外光源感兴趣,请拨打美国路阳中国地区免费咨询电话:4006-254-365,我们有专业工程师为您提供完整的解决方案。

上海路阳仪器有限公司
地址:上海市松江区泗砖南路255弄120号
邮箱:china@luyor.net
销售微信号:15317565658
咨询电话:021-64195798
QQ:574242291
技术微信号:18918042916

 微信咨询
微信咨询 微信关注
微信关注